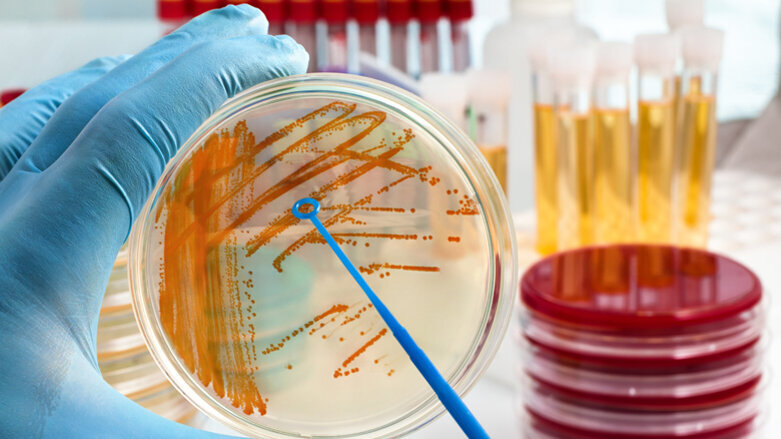
Studie: Zusammenhang von Zahnbehandlungen und Endokarditis

PARIS, Frankreich – Forscher untersuchten den Zusammenhang von invasiven zahnmedizinischen Maßnahmen, Antibiotikaprophylaxe und durch orale Streptokokken ausgelöste infektiöse Endokarditis in einer Studie.
Die Autoren einer aktuellen Studie, die im British Medical Journal erschienen ist, versuchten eine Lücke zu schließen: Bisher gibt es keinen ausreichenden wissenschaftlichen Beleg für die Wirksamkeit von Antibiotikaprophylaxe gegen eine infektiöse Endokarditis bei der folgenden Konstellation: Ein Patient hat eine künstliche Herzklappe und muss sich einem zahnmedizinischen Eingriff unterziehen.
Trotzdem gibt es in verschiedenen Ländern Richtlinien, nach denen eine Antibiotikaprophylaxe anzuwenden ist. In den USA und in Europa sollen Antibiotika bei invasiven zahnmedizinischen Eingriffen bedingt eingesetzt werden, u.a. dann, wenn der Patient eine künstliche Herzklappe besitzt. In Großbritannien soll die Antibiotikatherapie bei zahnmedizinischen Eingriffen generell nicht angewendet werden, außer der Einzelfall gebietet es.
Die Forscher untersuchten nun den Zusammenhang von invasiven zahnmedizinischen Maßnahmen, Antibiotikaprophylaxe und durch orale Streptokokken ausgelöste infektiöse Endokarditis. Basis für ihre bevölkerungsbezogene Kohorten- und Cross-over-Studie waren Daten aus dem französischen Gesundheitssystem.
Beide Studien unterscheiden sich zwar in der Signifikanz der Ergebnisse, zielen aber in dieselbe Richtung: Invasive zahnmedizinische Eingriffe können in Zusammenhang mit durch orale Streptokokken verursachter Endokarditis stehen, wenn die Patienten eine künstliche Herzklappe haben. Wie stark der Zusammenhang ist, bleibt aber weiterhin unklar. Zur Abschätzung der Wirksamkeit der Antibiotikaprophylaxe ist weitere Forschung mit größeren – möglicherweise länderübergreifenden – Datensätzen nötig.
Schlagwörter:
L'AQUILA, Italien – Italienische Forscher haben jüngst herausgefunden, dass sich eine vorhandene Parodontitis auf den Blutdruck auswirkt.
Sydney – Kopfschmerzen und saubere Zähne, das scheint auf den ersten Blick wenig zusammenzuhängen. Doch eine aktuelle Studie der Universität Sydney ...
LEIPZIG – Eine kürzlich durchgeführte Studie konnte eine Verbindung zwischen atopischer Dermatitis (AD) und Abnormalitäten in der Zahnentwicklung, wie ...
China – Karies zählt weltweit zu den häufigsten chronischen Erkrankungen und ihre Ursachen werden zunehmend vielschichtiger verstanden. Eine aktuelle ...
OKAYAMA, Japan – Bruxismus verursacht aufgrund der stark einwirkenden Kräfte der Kiefermuskulatur nicht nur Schmerzen und Verspannungen, die ...
SICHUAN, CHINA - Für die Trockenlegung eines Behandlungsgebietes im Mundraum gibt es – je nach Eingriff – verschiedene Varianten, beispielsweise durch ...
AMSTERDAM – Schlaflosigkeit, Angstzustände und nächtliches Zähneknirschen hängen miteinander zusammen. Wie die Symptome behandelt werden sollten, ist ...
KIEL - Organisieren, koordinieren, Verantwortung tragen – Führungskräfte müssen viel leisten und ein verlässlicher Faktor für Unternehmen und ...
GREIFSWALD – Zahnmediziner der Universitätsmedizin Greifswald veröffentlichen neue Erkenntnisse im englischen Fachjournal.
RUGBY/WARWICKSHIRE – Wie eine wissenschaftliche Studie der British Dental Health Foundation herausfand, haben Menschen mit Zahnfleischbeschwerden ein ...
Live-Webinar
Di. 23. Juni 2026
2:00 Uhr (CET) Vienna
Live-Webinar
Di. 23. Juni 2026
19:00 Uhr (CET) Vienna
Live-Webinar
Di. 23. Juni 2026
21:00 Uhr (CET) Vienna
Live-Webinar
Mi. 24. Juni 2026
14:00 Uhr (CET) Vienna
Live-Webinar
Mi. 24. Juni 2026
17:00 Uhr (CET) Vienna
Live-Webinar
Mi. 24. Juni 2026
18:30 Uhr (CET) Vienna
Dr. med. dent. Britta Hahn
Live-Webinar
Do. 25. Juni 2026
20:00 Uhr (CET) Vienna
Dr. Hatem Algraffee, Cat Edney



 Österreich / Österreich
Österreich / Österreich
 Bosnien und Herzegowina / Босна и Херцеговина
Bosnien und Herzegowina / Босна и Херцеговина
 Bulgarien / България
Bulgarien / България
 Kroatien / Hrvatska
Kroatien / Hrvatska
 Tschechien & Slowakei / Česká republika & Slovensko
Tschechien & Slowakei / Česká republika & Slovensko
 Frankreich / France
Frankreich / France
 Deutschland / Deutschland
Deutschland / Deutschland
 Griechenland / ΕΛΛΑΔΑ
Griechenland / ΕΛΛΑΔΑ
 Ungarn / Hungary
Ungarn / Hungary
 Italien / Italia
Italien / Italia
 Niederlande / Nederland
Niederlande / Nederland
 Nordic / Nordic
Nordic / Nordic
 Polen / Polska
Polen / Polska
 Portugal / Portugal
Portugal / Portugal
 Rumänien & Moldawien / România & Moldova
Rumänien & Moldawien / România & Moldova
 Slowenien / Slovenija
Slowenien / Slovenija
 Serbien & Montenegro / Србија и Црна Гора
Serbien & Montenegro / Србија и Црна Гора
 Spanien / España
Spanien / España
 Schweiz / Schweiz
Schweiz / Schweiz
 Türkei / Türkiye
Türkei / Türkiye
 Großbritannien und Irland / UK & Ireland
Großbritannien und Irland / UK & Ireland
 International / International
International / International
 Brasilien / Brasil
Brasilien / Brasil
 Kanada / Canada
Kanada / Canada
 Lateinamerika / Latinoamérica
Lateinamerika / Latinoamérica
 USA / USA
USA / USA
 China / 中国
China / 中国
 Indien / भारत गणराज्य
Indien / भारत गणराज्य
 Pakistan / Pākistān
Pakistan / Pākistān
 Vietnam / Việt Nam
Vietnam / Việt Nam
 ASEAN / ASEAN
ASEAN / ASEAN
 Israel / מְדִינַת יִשְׂרָאֵל
Israel / מְדִינַת יִשְׂרָאֵל
 Algerien, Marokko und Tunesien / الجزائر والمغرب وتونس
Algerien, Marokko und Tunesien / الجزائر والمغرب وتونس
 Naher Osten / Middle East
Naher Osten / Middle East

To post a reply please login or register